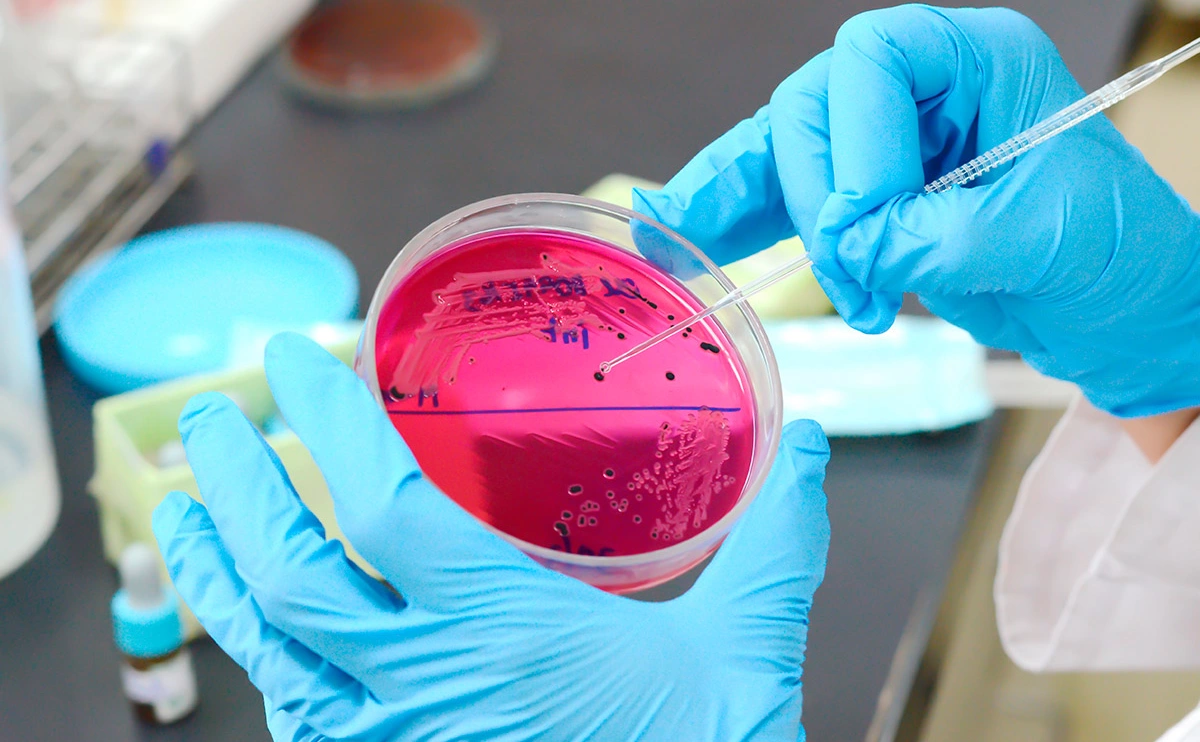
Yayah_Ai / Shutterstock

Роскачество обнаружило в курином фарше сальмонеллу и другие бактерии
Роскачество обнаружило в фарше бактерии, в том числе группы кишечной палочки
Фото: Yayah_Ai / Shutterstock
Сальмонеллы и другие бактерии, в том числе кишечную палочку, обнаружили в курином фарше, который производят в России, сообщили в Роскачестве. По результатам проверки только две из 18 торговых марок были признаны высококачественными.
«В ходе проверки были выявлены бактерии группы кишечной палочки, сальмонеллы, листерии, а мясо некоторых торговых марок отнесено к группе сомнительной свежести», — говорится в сообщении.
На маркер «Знак качества» могут претендовать только марки «Петелинка» и «Мясницкий ряд», при этом не соответствуют нормам 11 из 18 проверенных позиций.
В фарше марок «Троекурово» и «Перекресток» нашли листерии. У марок «Своя», «Вкусвилл», «Чернышихинское мясо» и «Ярославский бройлер» нашли патогенные микроорганизмы, в том числе сальмонеллы. В фарше еще трех торговых марок — «Троекурово», «Каждый день», «Чернышихинское мясо» — обнаружена кишечная палочка.
Товаром «сомнительной свежести» признали продукцию «Азбуки вкуса», «Чернышихинского мяса» и «Рококо», однако более половины других марок признали свежими.
Только у одного производителя фактическая масса нетто отличалась от заявленной — в упаковку фарша от «Агрокомплекса Выселковский» положили 478,6 г вместо 500 г.
При проверке на органолептические показания — визуальные и сенсорные критерии — массовых отклонений не выявили. В продукции пяти товарных марок есть несоответствие по запаху.
При проверке клетчатки нарушение выявили у одной торговой марки — углевод нашли в составе полуфабриката, однако на упаковке это указано не было.
В составе фарша всех торговых марок не обнаружили ДНК кукурузы, сою нашли только у одного производителя.
По данным Роскачества, бизнес уведомили о нарушениях. Некоторые компании уже назначили дополнительные проверки. Торговая сеть SPAR уведомила об утилизации партий товаров двух торговых марок, «Ашан» инициировал проверки всего ассортимента закупленных полуфабрикатов.
В компании «Вкусвилл» РБК сообщили, что эта проверка проходила весной, под нее попала партия от 24 апреля 2023 года. В компании сообщили, что фарш «Ярославского бройлера» — «продукт с высоким рейтингом, очень популярный среди наших покупателей» и его качество регулярно оценивается в лаборатории производителя и в собственной микробиологической лаборатории «Вкусвилла». Результаты тестов Роскачества компания получила спустя три месяца после реализации, когда провести перепроверку уже невозможно.
В компании сообщили, что провели дополнительную масштабную проверку с участием независимых испытательных центров органов государственного контроля — нарушений выявлено не было. «В июле на производстве прошла проверка Россельхознадзора, по результатам которой не нашлось нарушений требований технического регламента «О безопасности мяса птицы и продукции его переработки», — уточнили в компании.
В феврале Роскачество начало проверку роллов «Филадельфия». Тогда в организации сообщили, что сыр в этом блюде, изготовленном в ресторане «Якитория», ненастоящий, потому что содержит растительные жиры.
В марте Роскачество заявило о кишечной палочке в 40% роллов «Филадельфия». Кроме того, исследования показали, что во всех роллах выявили превышения по количеству микроорганизмов.
По словам главы Роскачества Максима Протасова, назвать роллы рыбным изделием нельзя, потому что в них содержится 9–31% рыбы от удельного веса продукта, вместо этого в них должно быть более 40%.








